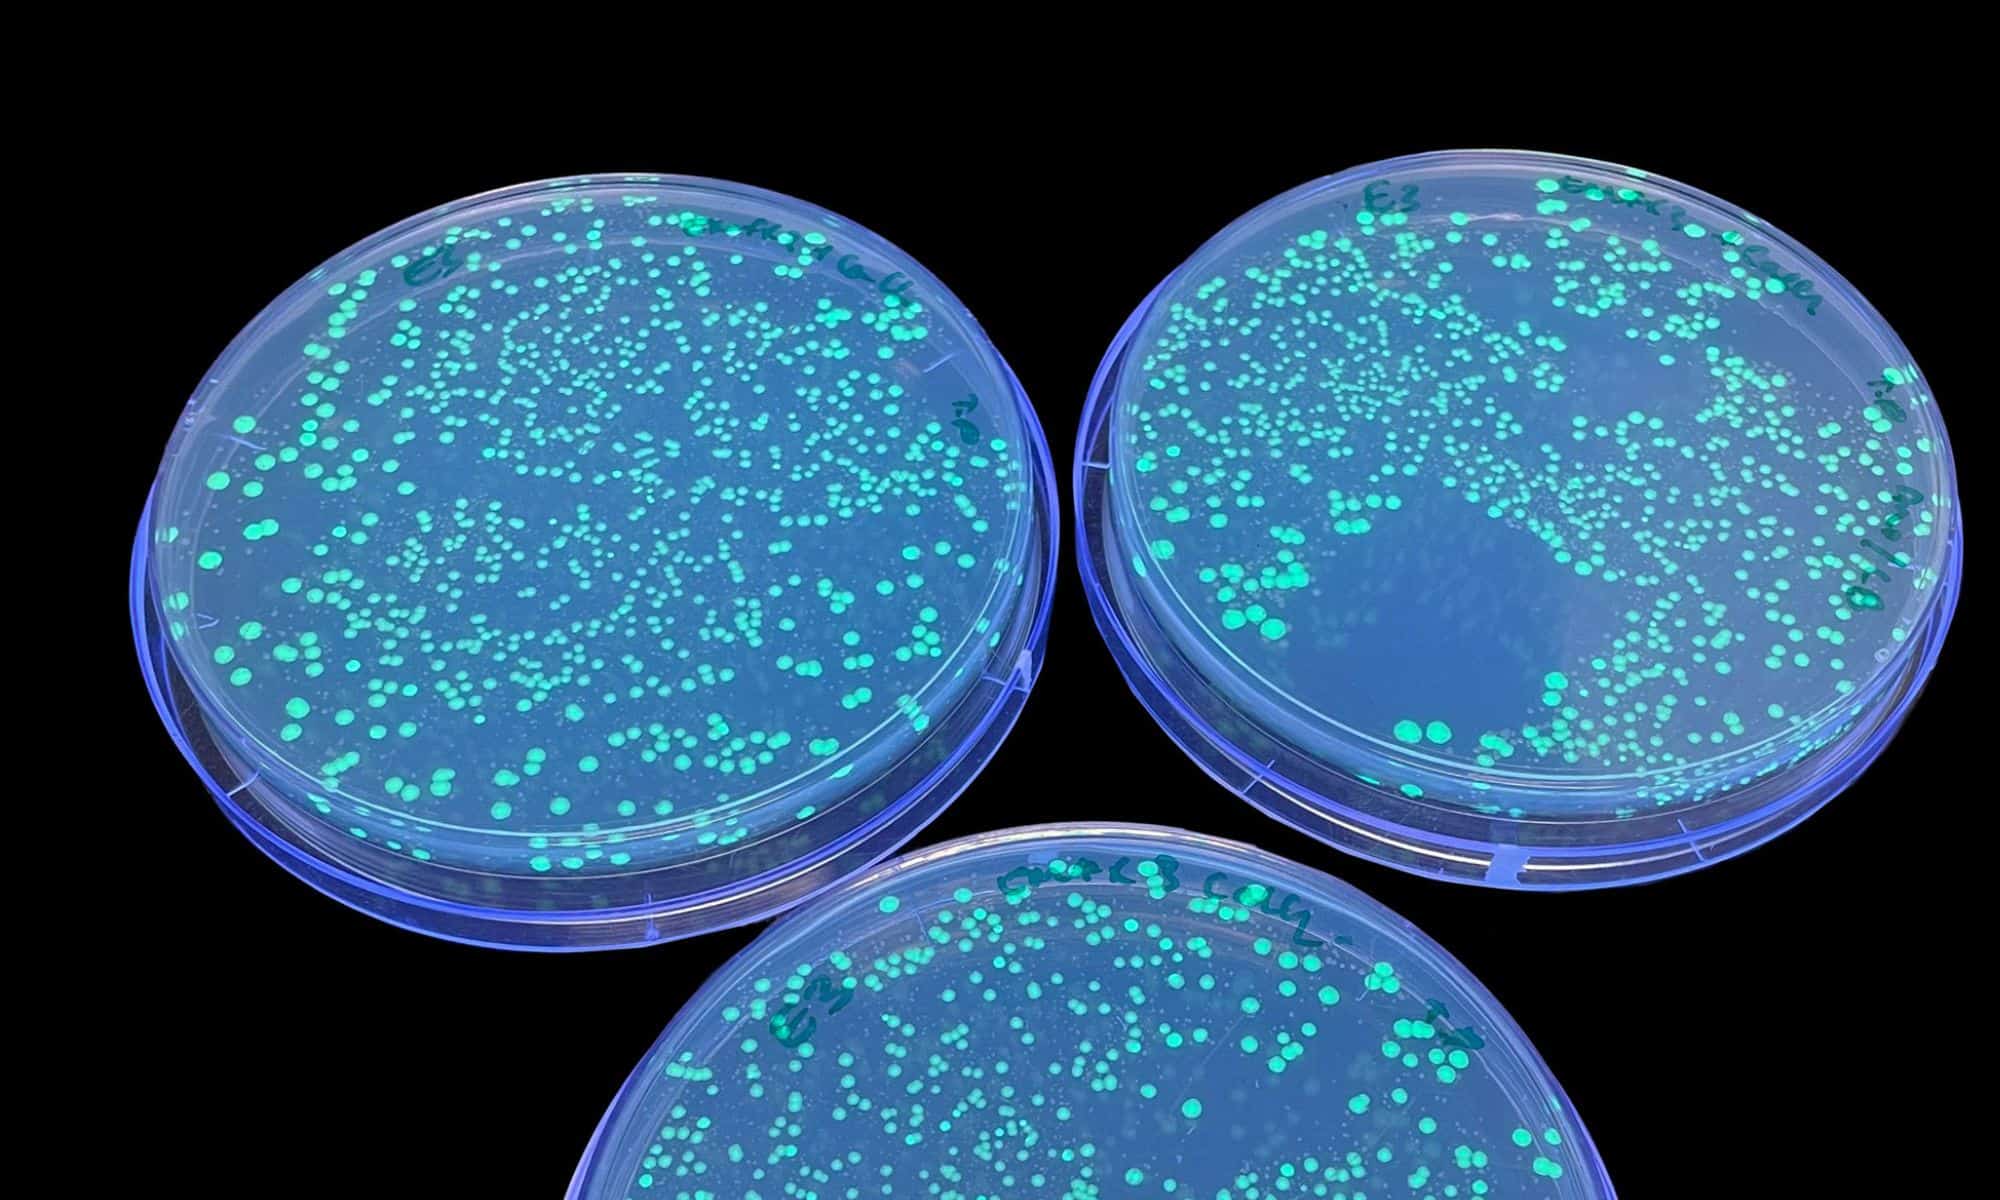

Radio waves offer gentler and more efficient way to alter bacteria DNA
Radio waves have been successfully harnessed to provide a less traumatic means to alter the DNA of bacteria cells.
Scientists from RMIT University together with peer Australian institutions and the US WaveCyte Biotechnologies say it renders the operation, used to create medicines including insulin, both gentler and more efficient than the usual industry techniques.
Normally chemicals or high temperatures are employed to open cell walls in order to insert DNA. Instead the team tested radio waves at 18 gigahertz frequency on E. coli bacterial cell walls, before the cells and continued to function healthily.
The study, published in Nano Letters built on earlier work with the Australian Centre for Electromagnetic Bioeffects Research that first demonstrated how high-frequency electromagnetic energy can make bacterial cells more permeable for a temporary period.
Now, the latest research has confirmed that the method could be used to deliver DNA effectively. It reported that 91% of the cells took on the new DNA after three minutes exposure to the radio waves.
By contrast, say the investigators, the industry standard ‘heat shock’ DNA insertion method results in an estimated 77% of the cells take on the DNA – many of which die soon after. Other, laser pulse techniques offer a gentler treatment but the number of cells taking on the new DNA plunges to less than 30% of cells used.
Lead author, RMIT School of Science professor Elena Ivanova, said of the new approach:
“Our novel, cost-effective method is shown to be highly efficient, but also gentler on the cells as no harsh chemicals or high temperatures are used in this process. As a result, the cell survival rate was higher than other techniques.”
Ivanova added that work would begin on translating the findings to a variety of potential applications. Other research has suggested the process can be used in eukaryotic cells – those with a defined nucleus common in all animals, fungi and plants. These include PC 12 cell line models featured in neuroscience research.
Added Ivanova: “Our focus now is on translating these findings. We have only scratched the surface of the wide range of drug delivery applications this approach could have in microbiome therapeutics and synthetic biology.”
RMIT has applied for intellectual property protection for the technique jointly with WaveCyte Biotechnologies, which specialises in developing cell and gene therapy technologies.
WaveCyte CEO Dr Steve Wanjara was enthusiastic about the potential of the new technique.
“This gentle and highly efficient method holds immense promise for enhancing the affordability and accessibility of critical therapies,” he said.
“We continue to actively work towards translating these findings into tangible applications, focusing on optimising the technique for mammalian cells. This research has the potential to positively impact millions of lives across the globe, and we are dedicated to making it a reality.”
Study first author, RMIT and Swinburne University’s Dr Tharushi Perera, said developing the application shed light on useful aspects of high frequency electromagnetic energy and was “hugely satisfying”.
“People hear electromagnetic energy and 5G and think it’s bad – possibly due to misinformation or lack of understanding – but, as we have shown here, there are actually beneficial applications,” she said.
“My hope is that this can open the door to new life-saving treatments in the long run and look forward to seeing its development.”




